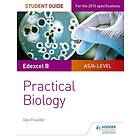

Compare prices and shops
We have found the product in 2 shops, 2 of which are PriceSpy partners and have a direct link to the shop. How we display prices and shops.
Insights
Price History
The graph shows the lowest price over time for the variant (such as color or size) that has been the cheapest at each point in time. Shipping and used products are not included. Read more about price history.
Product information
The best price for Edexcel A-level Biology Student Guide: Practical Biology right now is £10.93. PriceSpy compares deals and offers from 2 shops, online and local.
Basic information
Product name
Edexcel A-level Biology Student Guide: Practical Biology
Brand
Category